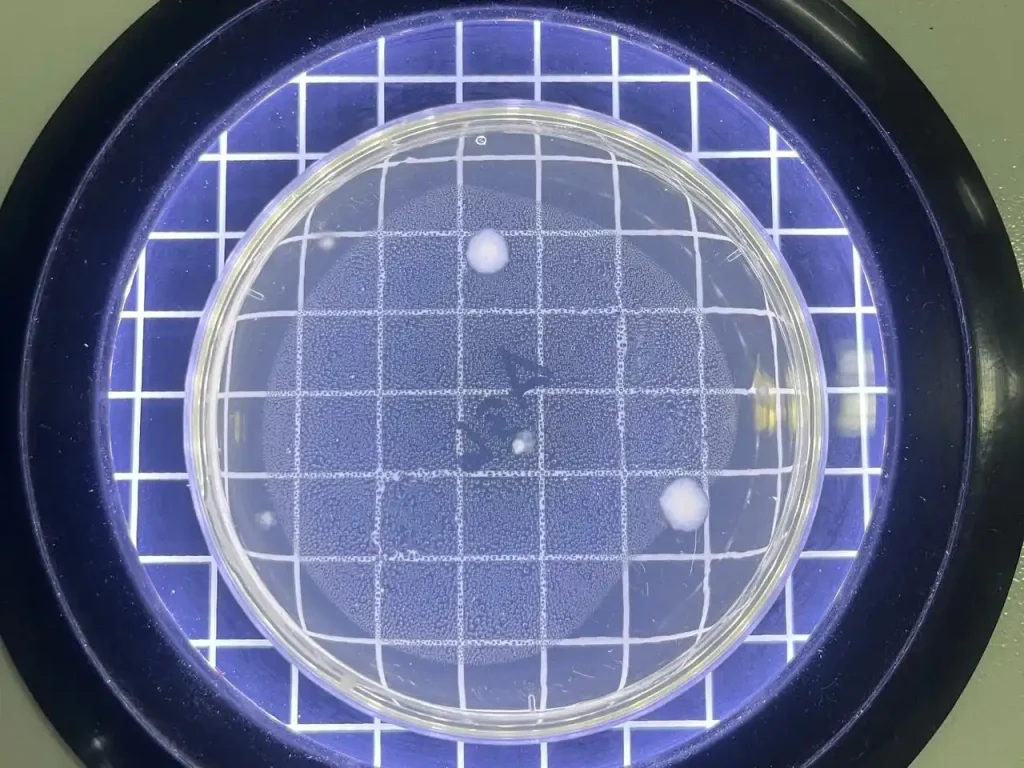
Disinfeksi Lead Apron Penting Cegah Infeksi di Radiologi_Dokumen Istimewa

Belajar Sistem Kontrol Melalui Simulasi Digital: Departemen Teknik Gelar Pengmas di SMAN 1 Kauman, Tulungagung

VOKASI NEWS – Fakultas Vokasi Universitas Airlangga menggelar pengabdian masyarakat di SMAN 1 Kauman Tulungagung melalui pembelajaran sistem kontrol otomatis berbasis simulasi digital. Departemen Teknik Fakultas Vokasi Universitas Airlangga kembali […]
Pengenalan Kearsipan: Wujudkan Generasi Muda Sadar Arsip di SMAN 1 Kauman, Tulungagung

VOKASI NEWS – Fakultas Vokasi Universitas Airlangga melaksanakan pengabdian masyarakat di SMAN 1 Kauman Tulungagung untuk meningkatkan literasi dan kesadaran kearsipan sejak dini. Departemen Teknik Fakultas Vokasi Universitas Airlangga melaksanakan […]
Student Outbound Fakultas Vokasi UNAIR Dorong Diplomasi Budaya di UniKL

VOKASI NEWS – Program Student Outbound Fakultas Vokasi UNAIR di Universiti Kuala Lumpur memperkuat diplomasi budaya dan wawasan global mahasiswa melalui pertukaran budaya lintas negara. Program Student Outbound Fakultas Vokasi […]
Disinfeksi Lead Apron Penting Cegah Infeksi di Radiologi
VOKASI NEWS – Disinfeksi lead apron dengan isopropil alkohol 70 persen efektif menurunkan jumlah bakteri dan mencegah infeksi nosokomial di instalasi radiologi rumah sakit. Fungsi Lead Apron di Instalasi Radiologi […]

